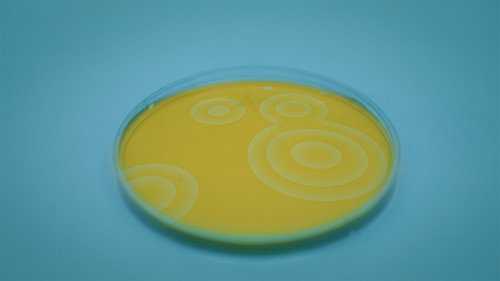
image1

Riproduzione Casuale
0%
|
Jun 28, 2026
|
Comedy, Drama
Featured Crew
Giovanni De Micco
Producer
Giovanni Luciano
Producer